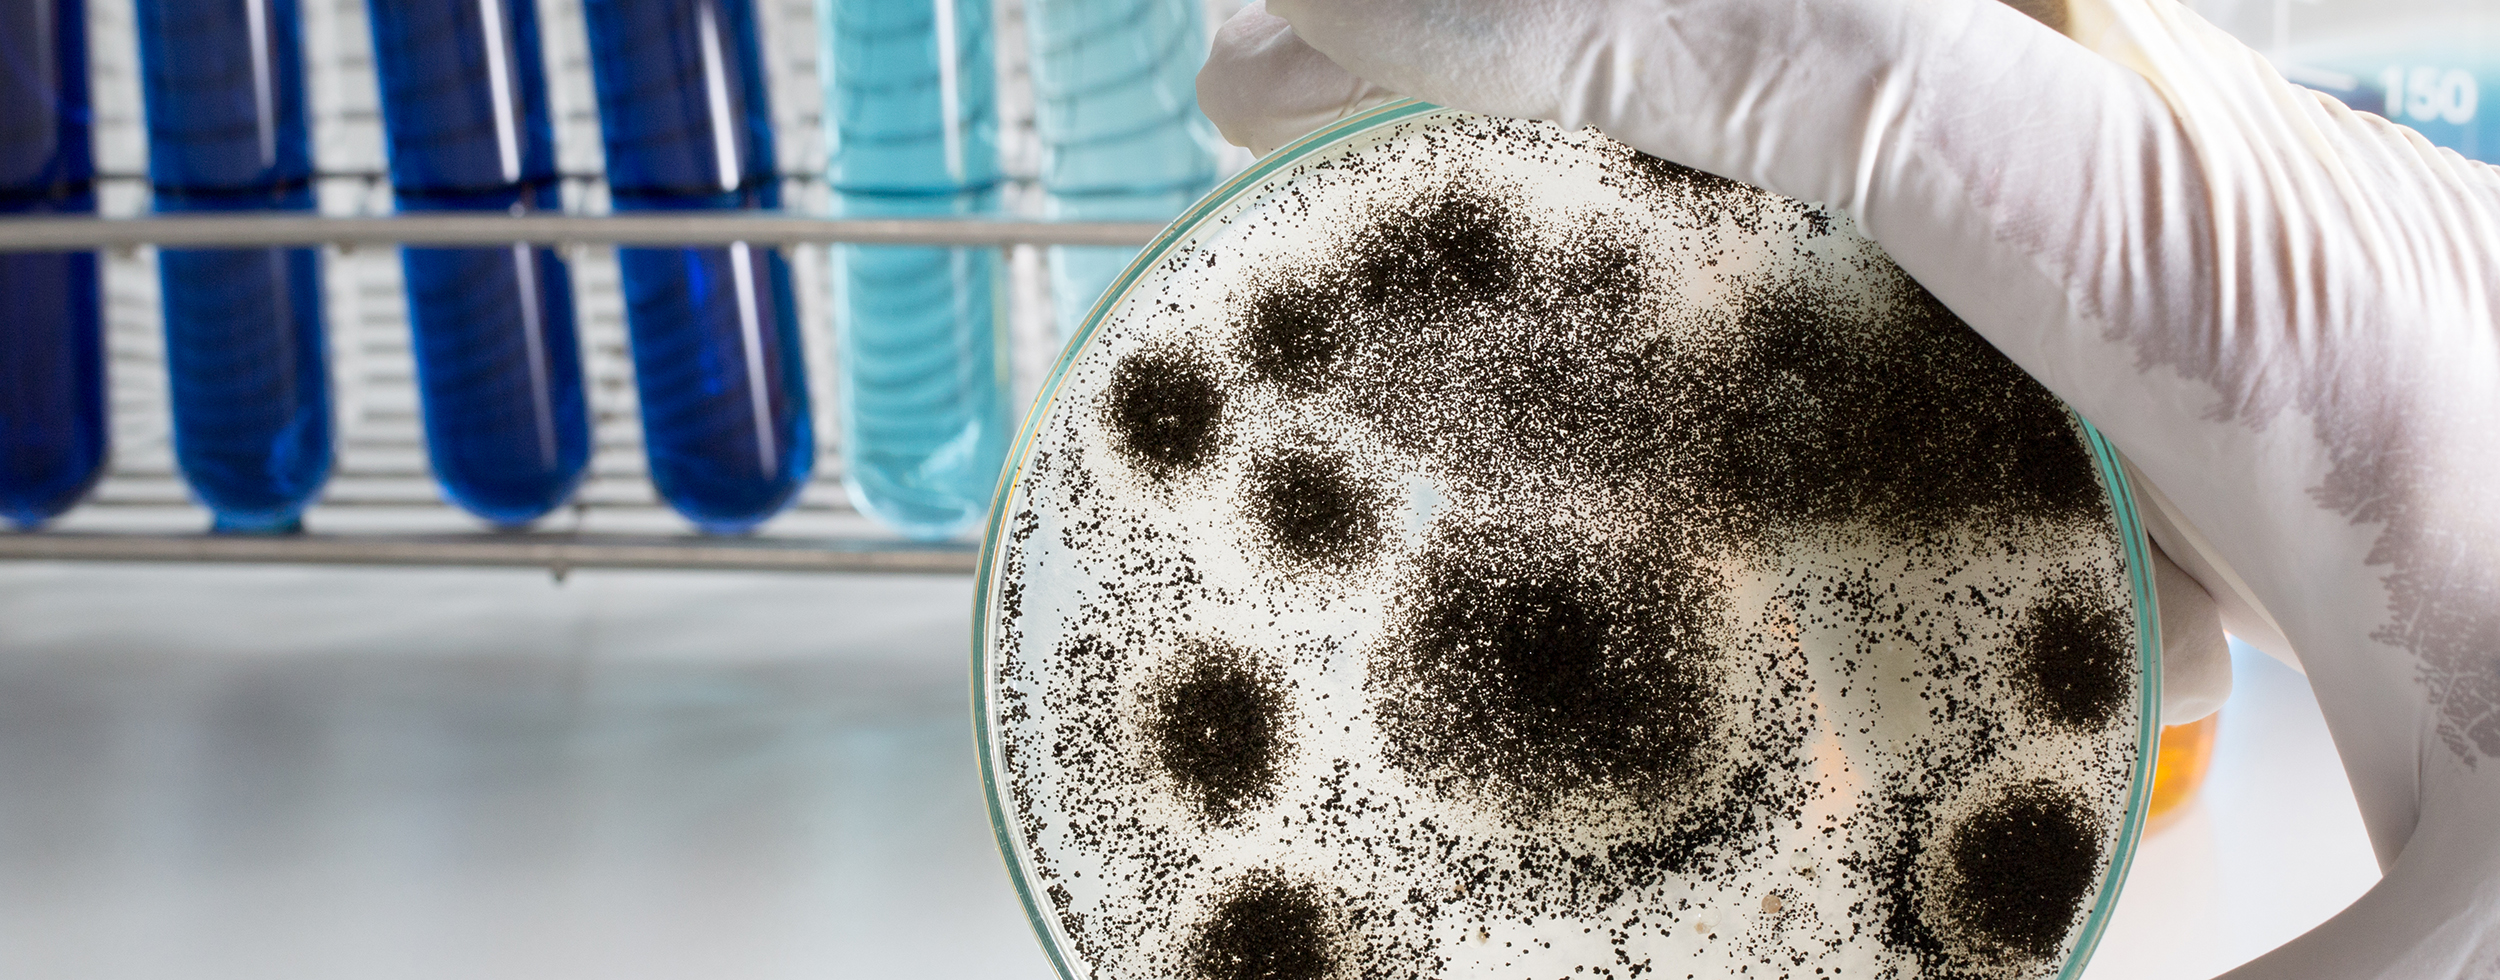

As the world goes digital, books and documents continue to hold their value as they hold vital parts of history in their pages. When documents and books receive water damage, document recovery doesn’t stop when the pages are dry. It also involves ensuring the longevity of the items in question by removing microbes. Of the microbes that may accumulate in documents and books, mold is one of the most damaging because it deteriorates paper and may spread to other documents. By taking the right steps to clean and dry documents as soon as possible, you’ll destroy and the microbes and prevent permanent damage.
Notice
You are now leaving Polygon Restoration's website and will be directed to another country in the group.
Do you want to proceed?